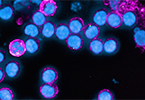

Presseinformationen 2021
Dezember
 15.12. 57/2021
15.12. 57/2021
Long COVID nach milder SARS-CoV-2 Infektion:
Krankheitsbild mit vielen Gesichtern
 06.12. 56/2021
06.12. 56/2021
ExpertInneninterview zu Öffnung der Skipisten
 01.12. 55/2021
01.12. 55/2021
„Die Nervosität bei den Kindern steigt“
November
 16.11. 54/2021
16.11. 54/2021
Mobile Hilfe für die Psyche mit der Help@Covid App
 10.11. 53/2021
10.11. 53/2021
„Diabetes ist eine ernst zu nehmende, aber gut behandelbare Erkrankung“
 09.11. 52/2021
09.11. 52/2021
Mobile Hilfe für die Psyche mit der ersten Help@Covid App
 03.11 51/2021
03.11 51/2021
Schmerz, lass nach
Oktober
 28.10. 50/2021
28.10. 50/2021
Tiroler Forscher entschlüsselten wichtiges Neurofibromin-Gen
 21.10. 49/2021
21.10. 49/2021
Impfkampagne: Stimmt es, dass die COVID-Impfung…?
 18.10. 48/2021
18.10. 48/2021
In eigener Sache: Stellungnahme der Medizinischen Universität Innsbruck
 12.10. 47/2021
12.10. 47/2021
Grundlagenforschung: Chromatin-Protein CHD1 steuert Hungerwahrnehmung im Fliegenhirn
 06.10. 46/2021
06.10. 46/2021
Jahrestagung des italienisch-österreichischen Interreg-Kooperationsprojekts INCardio: „Gebrochene Herzen heilen“
 05.10.2021 45/2021
05.10.2021 45/2021
Positive Entwicklung und gesteigerte Sichtbarkeit: Rektoratsteam setzt Erfolgskurs an der Medizin Uni Innsbruck fort
September
 29.09. 44/2021
29.09. 44/2021
Rektoratsteam tritt zweite Amtszeit an: „Erfolgskurs fortsetzen“
 22.09. 43/2021
22.09. 43/2021
„Viele Frauen fragen, ob es eine Studie für sie gibt“
August 2021
 31.08. 42/2021
31.08. 42/2021
Kombinierte Tumorimpfung verstärkt krebsabtötende Immuneffekte
 17.08. 41/2021
17.08. 41/2021
Hoher Anteil an zytotoxischen T-Zellen in COVID-19-PatientInnen mit mildem Verlauf
 10.08. 40/2021
10.08. 40/2021
„Mischimpfung verstärkt die Immunantwort“
 06.08. 39/2021
06.08. 39/2021
„Erster genetischer Beweis für Holocaust-Verbrechen in Ostpolen
 04.08. 38/2021
04.08. 38/2021
„Die Corona-Impfung macht genauso wenig unfruchtbar wie ein Schnupfen“
Juli 2021
 28.07. 37/2021
28.07. 37/2021
Häufige Lp(a)-Genmutation reduziert Herzinfarkt-Risiko
 21.07. 36/2021
21.07. 36/2021
Aufnahmeverfahren zum Medizinstudium: 12.777 nahmen teil
Foto- und Bildmaterial zum Medizin Aufnahmeverfahren in Innsbruck am 21.07.2021
 15.07. 35/2021
15.07. 35/2021
Aufnahmeverfahren zu den Diplomstudien der Humanmedizin und Zahnmedizin in Innsbruck
 09.07. 34/2021
09.07. 34/2021
Preis des Fürstentums Liechtenstein für wissenschaftliche Forschung verliehen
 01.07. 33/2021
01.07. 33/2021
Bauchbinde soll Blutdruck regulieren und Stürze verhindern
Juni 2021
 22.06. 32/2021
22.06. 32/2021
Grauer-Star-Operation verbessert Fahrsicherheit im Alter
 22.06. 31/2021
22.06. 31/2021
Neuer Biomarker bei Multipler Sklerose ermöglicht frühe Risikoeinschätzung und gezielte Therapiewahl

16.06. 30/2021
„Die COVID-Impfung bringt die Krebsforschung voran“
 12.06. 29/2021
12.06. 29/2021
Klinische Studie zu Blutdrucksenkern bei COVID-19: Pausieren beschleunigt möglicherweise die Genesung
10.06. 28/2021
10.06. 28/2021
Antikörper bleiben auch bei Älteren lern- und abwehrfähig
 07.06. 27/2021
07.06. 27/2021
Corona-Lockerungen: Wie gut erholt sich die Kinderpsyche?
 01.06. 26/2021
01.06. 26/2021
Gemeinsame Pressemitteilung: 833 Millionen Investment in Tiroler Gesundheit
Mai 2021
 31.05. 25/2021
31.05. 25/2021
Bau- und Investitionsprogramm Klinik 2035
 27.05. 24/2021
27.05. 24/2021
ExpertInneninterview zum Frauengesundheitstag: „Wir brauchen auf Frauen zugeschnittene Angebote bei Long-Covid“
 20.05. 23/2021
20.05. 23/2021
COVID-19: Humanes 3D-Modell enthüllt neues Angriffsziel zur Verhinderung schwerer Verläufe
 18.05. 22/2021
18.05. 22/2021
Abwasseranalyse 2020: Cannabis und Kokain nach wie vor dominierend, moderater Anstieg des Metamphetaminkonsums
 07.05. 21/2021
07.05. 21/2021
Covid-19 & Haut: Vom Nesselausschlag bis zu Covid-Zehen, es gibt noch viele offene Fragen
April 2021
 20.04. 20/2021
20.04. 20/2021
MedAT-Aufnahmeverfahren zum Medizinstudium: 17.823 Anmeldungen
 13.04. 19/2021
13.04. 19/2021
Spermidin verbessert die Gedächtnisleistung, zeigt ein Forschungsteam aus Graz, Berlin und Innsbruck
März 2021
 25.03. 18/2021
25.03. 18/2021
Ergebnisse der 3. Untersuchungsrunde der Schul-SARS-CoV-2-Monitoringstudie (Gurgelstudie) liegen vor
 23.03 17/2021
23.03 17/2021
Neue Erkenntnisse Tiroler Covid-19-Kinderstudie: „Kinder und Jugendliche sind deutlich stärker belastet.“
 18.03 16/2021
18.03 16/2021
Tiroler Universitäten starten neues PhD-Programm für digitale medizinische Bildgebung und Bild-gestützte Therapien
 16.03. 15/2021
16.03. 15/2021
Update zur Tiroler Covid-19-Kinderstudie: Verlaufserkenntnisse zu Auswirkungen auf die psychische Gesundheit
 16.03. 14/2021
16.03. 14/2021
„Während und in Folge einer COVID-19-Erkrankung kann es zu Schlafstörungen kommen.“
 10.03. 13/2021
10.03. 13/2021
Neue Kombinationsstrategie mit dendritischen Zellen könnte Immuntherapie beim Melanom optimieren
 08.03. 12/2021
08.03. 12/2021
Woche des Gehirns vom 15. – 19. März 2021 in Innsbruck: Vorträge finden erstmals online statt
 05.03. 11/2021
05.03. 11/2021
Medizin Uni Innsbruck fordert mehr Diversität
 03.03. 10/2021
03.03. 10/2021
Kardiologie-Kongress Innsbruck: COVID-19 im Zentrum
Februar 2021
 24.02. 09/2021
24.02. 09/2021
Zusammenlegung, neues Unfallmuster und Covid-19: Herausforderungen in der Traumatologie und Orthopädie
 23.02. 07/2021
23.02. 07/2021
Periodische Fiebersyndrome
 19.02. 06/2021
19.02. 06/2021
Aktuelle Entwicklungen an der Univ.-Klinik für Orthopädie und Traumatologie in Innsbruck
 18.02. 05/2021
18.02. 05/2021
Folgestudie in Ischgl: „Immunität auch nach acht Monaten stabil“
 15.02. 04/2021
15.02. 04/2021
Folgestudie: Neue Erkenntnisse zur Dauer der Immunität der Ischgler Bevölkerung
 01.02. 03/2021
01.02. 03/2021
Krebs und COVID-19: „Definitive Impfempfehlung!“
Jänner 2021
 28.01. 02/2021
28.01. 02/2021
Was wollen Sie über das Gehirn wissen?
 13.01. 01/2021
13.01. 01/2021
Bauchweh – wenn die Welt mich nicht versteht
PR & Medien
Kontakt:
Mag.a Doris Heidegger
Tel.: +43 (0)512/9003-70083
E-Mail: doris.heidegger@i-med.ac.at
Dr.in Barbara Hoffmann-Ammann
Tel.: +43 (0)512/9003-71830
E-Mail: barbara.hoffmann@i-med.ac.at
Mag.a Theresa Mair
Tel.: +43 512 9003 71833
E-Mail: theresa.mair@i-med.ac.at



